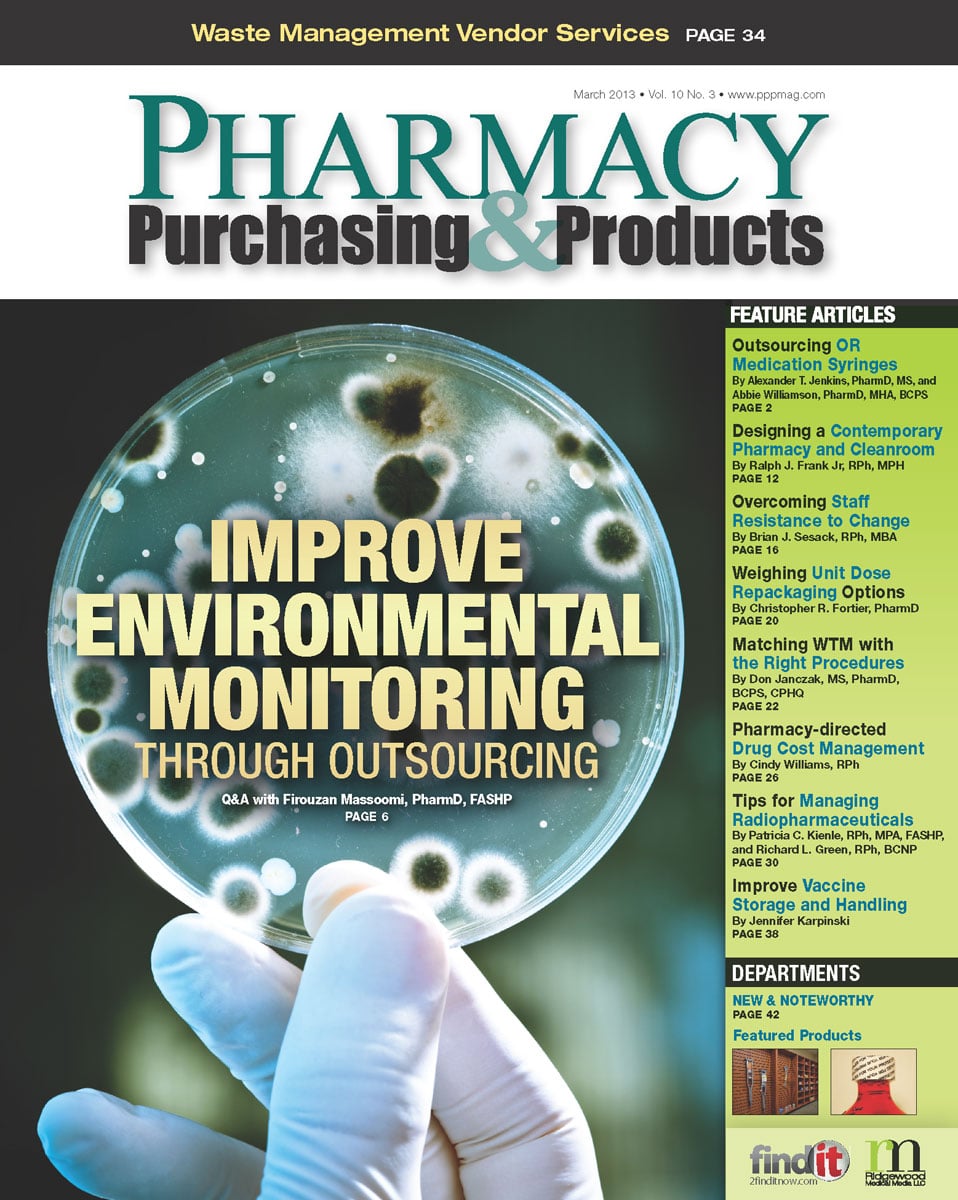

- Show Menu
- Contact Us
- FAQs
- Reader Service
- Survey Data
- Survey Winners
- Testimonials
- Upcoming Events
- Webinars
- White Papers
Issues
Pharmacy Purchasing & Products (PP&P) is published twelve times a year. The print edition of Pharmacy Purchasing & Products is free to qualified requesters.
To request your free subscription, click here.
2026
2025
2024
2023
2022
2021
2020
2019
2018
2017
2016
2015
2014
2013
2012
2011
2010
2009
2008
2007
2006
2005
2004
2013 Issues

December 2013
Vol. 10 No. 12 | Articles: 14

October 2013
Vol. 10 No. 10 | Articles: 9

September 2013
Vol. 10 No. 9 | Articles: 9

July 2013
Vol. 10 No. 7 | Articles: 13

June 2013
Vol. 10 No. 6 | Articles: 11

May 2013
Vol. 10 No. 5 | Articles: 14

April 2013
Vol. 10 No. 4 | Articles: 9
March 2013
Vol. 10 No. 3 | Articles: 12

February 2013
Vol. 10 No. 2 | Articles: 7

January 2013
Vol. 10 No. 1 | Articles: 8
Recent Popular Articles
About Us
Pharmacy Purchasing & Products Ridgewood Medical Media, LLC
Quick Links
Subscribe to Our Email Newsletter!
© 2005 - 2026 PP&P Magazine - Pharmacy Purchasing & Products.
All rights reserved.





















